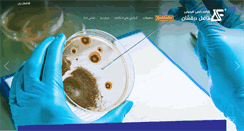
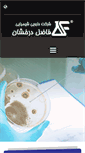

FAZEL-PJS.COM
Fazel Derakhshan. – pharmaco-chemical Coشرکت دارویی شیمیایی فاضل درخشان
http://www.fazel-pjs.com/

شرکت دارویی شیمیایی فاضل درخشان
http://www.fazel-pjs.com/
TODAY'S RATING
>1,000,000
Date Range
HIGHEST TRAFFIC ON
Monday

LOAD TIME
2.2 seconds
16x16
32x32

64x64

128x128

160x160

192x192

256x256
Mizban Network
Mizban Behin Ertebatat Faragir
# 140 Molas●●●●●●●●●●●econd Floor
Te●●an , Tehran, 1435915361
IR
View this contact
Mizban Network
Behin Ertebatat Faragir Mizban
# 140 Molas●●●●●●●●●●●econd Floor
Te●●an , Tehran, 1435915361
IR
View this contact
Mizban Network
Behin Ertebatat Faragir Mizban
# 140 Molas●●●●●●●●●●●econd Floor
Te●●an , Tehran, 19437
IR
View this contact
19
YEARS
0
MONTHS
11
DAYS

TUCOWS DOMAINS INC.
WHOIS : whois.tucows.com
REFERRED : http://domainhelp.opensrs.net
PAGES IN
THIS WEBSITE
16
SSL
EXTERNAL LINKS
0
SITE IP
149.202.100.48
LOAD TIME
2.232 sec
SCORE
6.2
Fazel Derakhshan. – pharmaco-chemical Co | fazel-pjs.com Reviews
https://fazel-pjs.com
شرکت دارویی شیمیایی فاضل درخشان
 fazel-pjs.com
fazel-pjs.com
جرمی ساید پی دامداری
http://www.fazel-pjs.com/index.php/products/geremicide-pranching
ارسال نظرات و پیشنهادات. تیت پوش درخشان دامداری. جرمی ساید . اچ بیمارستان. جرمی ساید . اچ صنایع غذایی. جرمی ساید . اچ میوه و سبزی. جرمی ساید . پی دامداری. جرمی ساید . پی مرغداری. گلیسیرین یده و تنطورید دام. نظر شما در مورد کیفیت محصولات ما چیست؟ سازمان دامپزشکی کل کشور. وزارت بهداشت،درمان وآموزش پزشکی. موسسه واکسن و سرم سازی. موسسه تحقیقات شیلات ایران. موسسه استاندارد و تحقیقات صنعتی ایران. دانشکده علوم پزشکی دانشگاه تهران. مرکز ملی تحقیقات مهندسی ژنتیک و تکنولوژی زیستی. دانشکده دامپزشکی دانشگاه تهران.
آزمایشات
http://www.fazel-pjs.com/index.php/tests
ارسال نظرات و پیشنهادات. تیت پوش درخشان دامداری. جرمی ساید . اچ بیمارستان. جرمی ساید . اچ صنایع غذایی. جرمی ساید . اچ میوه و سبزی. جرمی ساید . پی دامداری. جرمی ساید . پی مرغداری. گلیسیرین یده و تنطورید دام. نظر شما در مورد کیفیت محصولات ما چیست؟ سازمان دامپزشکی کل کشور. وزارت بهداشت،درمان وآموزش پزشکی. موسسه واکسن و سرم سازی. موسسه تحقیقات شیلات ایران. موسسه استاندارد و تحقیقات صنعتی ایران. دانشکده علوم پزشکی دانشگاه تهران. مرکز ملی تحقیقات مهندسی ژنتیک و تکنولوژی زیستی. دانشکده دامپزشکی دانشگاه تهران.
آکواجرم آبزیان
http://www.fazel-pjs.com/index.php/products/aqua
ارسال نظرات و پیشنهادات. تیت پوش درخشان دامداری. جرمی ساید . اچ بیمارستان. جرمی ساید . اچ صنایع غذایی. جرمی ساید . اچ میوه و سبزی. جرمی ساید . پی دامداری. جرمی ساید . پی مرغداری. گلیسیرین یده و تنطورید دام. نظر شما در مورد کیفیت محصولات ما چیست؟ سازمان دامپزشکی کل کشور. وزارت بهداشت،درمان وآموزش پزشکی. موسسه واکسن و سرم سازی. موسسه تحقیقات شیلات ایران. موسسه استاندارد و تحقیقات صنعتی ایران. دانشکده علوم پزشکی دانشگاه تهران. مرکز ملی تحقیقات مهندسی ژنتیک و تکنولوژی زیستی. دانشکده دامپزشکی دانشگاه تهران.
البان دست
http://www.fazel-pjs.com/index.php/products/hand-elban
ارسال نظرات و پیشنهادات. تیت پوش درخشان دامداری. جرمی ساید . اچ بیمارستان. جرمی ساید . اچ صنایع غذایی. جرمی ساید . اچ میوه و سبزی. جرمی ساید . پی دامداری. جرمی ساید . پی مرغداری. گلیسیرین یده و تنطورید دام. نظر شما در مورد کیفیت محصولات ما چیست؟ سازمان دامپزشکی کل کشور. وزارت بهداشت،درمان وآموزش پزشکی. موسسه واکسن و سرم سازی. موسسه تحقیقات شیلات ایران. موسسه استاندارد و تحقیقات صنعتی ایران. دانشکده علوم پزشکی دانشگاه تهران. مرکز ملی تحقیقات مهندسی ژنتیک و تکنولوژی زیستی. دانشکده دامپزشکی دانشگاه تهران.
نقشه
http://www.fazel-pjs.com/index.php/about-us/map-of-company
ارسال نظرات و پیشنهادات. تیت پوش درخشان دامداری. جرمی ساید . اچ بیمارستان. جرمی ساید . اچ صنایع غذایی. جرمی ساید . اچ میوه و سبزی. جرمی ساید . پی دامداری. جرمی ساید . پی مرغداری. گلیسیرین یده و تنطورید دام. نظر شما در مورد کیفیت محصولات ما چیست؟ سازمان دامپزشکی کل کشور. وزارت بهداشت،درمان وآموزش پزشکی. موسسه واکسن و سرم سازی. موسسه تحقیقات شیلات ایران. موسسه استاندارد و تحقیقات صنعتی ایران. دانشکده علوم پزشکی دانشگاه تهران. مرکز ملی تحقیقات مهندسی ژنتیک و تکنولوژی زیستی. دانشکده دامپزشکی دانشگاه تهران.
TOTAL PAGES IN THIS WEBSITE
16
BLOGFA.COM
از ارائه خدمات در این آدرس به یکی از دلایل زیر معذوریم. تخطی از قوانین و توافقنامه استفاده از خدمات سایت. دستور مراجع قانونی جهت مسدود سازی وبلاگ. انتشار محتوای غیر اخلاقی یا محتوایی که براساس قوانین کشور تخلف است.
![]() fazel-imageworld.mihanblog.com
fazel-imageworld.mihanblog.com
سایت اصلی خرید مانتو زمستانی دخترانه طرح کارولین
سایت اصلی خرید مانتو زمستانی دخترانه طرح کارولین. خرید مانتو خنک برای زنان باردار و حامله طرح شامین. نویسنده : baaz bahbaz. تاریخ : 06:12 ق.ظ - جمعه 16 آبان 1393. بدون هیچ نگرانی و دغدغه ای ، از مدل های جدید لباس مجلسی و لباس شب ما دیدن کنید و پس از ارزیابی کامل بهترین گزینه خود را انتخاب فرمایید یکی از مهمترین عوامل زیبا به نظر رسیدنخانم های ایرانی پوشش سر آنهاستمطمئن باشید با دیدن این مدل ها خرید مانتو شمابه دنبال مدل های جدید و متنوع هستید؟ برچسب محصول : خرید مانتو بارداری. خرید مانتو حراجی 2015.
زنده یاد فاضل خداداد
زنده یاد فاضل خداداد. In Memory of Fazel Khodadad. Subscribe to: Posts (Atom). Awesome Inc. theme. Powered by Blogger.
![]() fazel-neeufseeptkaat.skyrock.com
fazel-neeufseeptkaat.skyrock.com
Their Profile - fazel-neeufseeptkaat - Skyrock.com
The position of the blocks have been saved. Did you like this profile? Tue, October 29, 2013. My star sign : Pisces. Post to my blog. Here you are free.
دوستداران کربلائی فاضل پرکم
دوستداران کربلائی فاضل پرکم. هروقت دیدی تنها شدی بدون خدا همه رو بیرون کرده تا خودت باشی و خودش . ثامن تم قالب و ابزار مذهبی رایگاه. بشارت 110 از جنس پلاک. پایگاه فرهنگی دختر چادری. 1608;صیت شهدا. 1585;وزشمار فاطمیه. مداحی های محرم کربلائی فاضل پرکم. کربلائی فاضل پرکم-مراسم هفتگی5دی92-هیات قاسم بن الحسن. کربلائی فاضل پرکم-شب هفتم محرم-هیات محبان اهل البیت(ع). کربلائی فاضل پرکم-شب ششم محرم-هیات محبان اهل البیت(ع). کربلائی فاضل پرکم-شب چهارم محرم-هیات محبان اهل البیت(ع). کربلائی فاضل پرکم-شب قدر اول رمضان92.
Fazel Derakhshan. – pharmaco-chemical Co
شرکت دارویی شیمیایی فاضل درخشان(سهامی خاص). شماره تماس : ٠٢١٦٦٩٣٧٥٥٢. پست الکترونیک: info@fazel-pjs.com. اشتهارد ، شهرک صنعتی. مشاهده در نقشه گوگل. نمایندگی های پخش استانی. توسط دانشگاه ها و مراکز معتبر علمی. جهت استفاده در دامپروری ها. جهت استفاده در مرغداری ها. جهت استفاده در بیمارستان ها. جهت استفاده در صنایع غذایی. مورد استفاده در شهرداری ها. اولین تولیدکننده مواد ضدعفونی غیرسمی و غیرسرطانزا در ایران (تأسیس ۱۳۷۵ - سهامی خاص). اولین تولیدکننده مواد ضدعفونی غیرسمی و غیرسرطانزا در ایران. ضد عفونی کننده ...
موسسه آموزش عالی فاضل
جهت دریافت جدیدترین اخبار و اطلاعیه ها و عضویت در خبرنامه کلیک نمایید. شیراز- پارامونت - ابتدای خیابان قصرالدشت - کوچه 1. 071-32353016) - ( 071-32359902) - (071-32343234-6). تمامی حقوق مادی و معنوی این سایت متعلق به موسسه آموزش عالی آزاد فاضل می باشد.
Fazel Ana sayfa
FAZEL ELEKTRİK VE AYDINLATMA. FAZEL ALTERNATİF ENERJİ SİSTEMLERİ. FAZEL ISI SES SU YATILIMI VE DIŞ CEPHE. FAZEL SIHHI TESİSAT VE KALORİFER SİSTEMLERİ. FAZEL ALARM HIRSIZLIK VE KAMERA SİSTEMLERİ. Kaç para peşinatla daire satın alırsınız? 1 $ = 4,01 TL. 1 € = 4,97 TL.
دکتر نویدِ فاضل
تارنمای دکتر نوید فاضل. Verzeichnis der Partizipien im Persischen. Vereinigung der Iranischen Ärzte und Zahnärzte in der Bundesrepublik Deutschland e. V. Association des Chercheurs Iraniens - ACI. Verein Deutsch-Iranische Kinderhilfe e.V. Persische Schule des Vereins Freunde der iranischen Sprachen und Kultur e.V. جدول بنهای فعل در پارسی. کانون پزشکان و دندانپزشکان ایرانی مقیم آلمان. انجمن خیری هی ایران - آلمان. مدرسهی فارسی انجمن دوستداران زبان و فرهنگ ایران در دوسلدورف. در دانشگاه تربیت معل م سبزوار.
単発バイトを始めてみよう | 単発バイトとの出会い